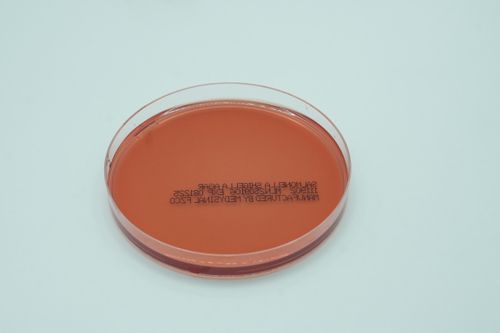

%201.png)



































%20Agar%201.png)

%20Slants%201.png)

















Sabouraud Dextrose Agar/Trypticase Soy Agar Bi-plate is used for the isolation, cultivation, and maintenance of non-pathogenic and pathogenic species of fungi and yeasts and general purpose medium which supports the growth of non-fastidious as well as moderately fastidious micro-organisms.
Pack Size: 10
Certifications: U.A.E MOH, CE.



